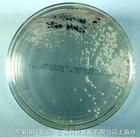
短乳桿菌

基本信息
拉丁名:Lactobacillus brevis英文名:
其它名:
分類地位:菌物界 > 厚壁菌門 > 芽孢桿菌綱 > 乳桿菌目 > 乳桿菌科 > 短乳桿菌屬
保護級別:未列入
瀕危等級:無危
可信度:2級可信度
野生馴化:野生
水生陸生:陸生
重慶特有種:否
重慶模式種:否
產地:
引進來源:CNIFFI
引進時間:
市外分布:
特有地區:
識別特徵:
CNIFFI 分離(D-8);分離自泡菜,用於將葡萄糖轉化成果糖;培養基8,最適培養溫度30℃生物現狀
保護及保存現狀:人工保存
主要用途和價值:
葡萄糖轉化成果糖
開發利用現狀:
不詳
保護建議:
不詳
遺傳多樣性:
不詳
短乳桿菌的培養
材 料
短乳桿菌 穿刺接種置於4℃冰櫃 中保藏。培養基
MRS基礎培養基組成:葡萄糖20g;蛋白腖10g;牛肉膏10g;酵母膏5g;檸檬酸氫二銨2g,蒸餾水1000ml實驗藥品
乳酸、 氫氧化鈉 、 鄰苯二甲酸氫鉀 混合磷酸鹽、 四硼酸鈉,乙醇、 硫酸銨、 磷酸氫二鈉、 大豆蛋白腖 、 乳糖 、 碳酸鈣等。實驗儀器
蒸汽滅菌鍋 恆溫隔水式培養箱 恆溫振盪器方法
⑴測定方法將穿刺接種並保藏於 4℃下的短乳桿菌轉接至裝有已滅菌液體培養基的試管中,35℃下靜置培養16h ,連續活化2次至鏡檢無雜菌後,轉接至裝有 MRS液體培養基的錐形瓶中。
⑵活菌計數
以 MRS培養基為基礎培養基, 採用梯度稀釋平板法計數。
⑶OD值測定
將發酵液在600nm下測定OD值 。
培養條件
⑴溫度隨著溫度的升高,培養16h後的菌株菌體含量增大,且在35℃時,菌體含量有最大值
⑵PH
菌株在不同的初始PH環境中培養18h後,菌體含量差異很大,其適宜生長的PH值均在5-7之間,且最適PH值為6.5,此條件下OD值最大。
⑶鹽濃度
菌株在不同的鹽濃度環境中培養16h後,菌體含量差異顯著,當含鹽量為0時,菌體含量最大,且波動範圍較大。從曲線得出, 短乳桿菌在2%-4%的鹽濃度環境中生長較好 。
總結
通過對短乳桿菌的生長特性研究得:短乳桿菌培養最適合PH為6.5,恆溫振盪培養且培養溫度為35℃菌物界(三)
| “菌物界”這個名詞是我國學者裘維蕃等於1990年提出的,並已得學術界的一定支持,這是指與動物界,植物界相併列的一大群無葉綠素,依靠細胞表面吸收有機養料,細胞壁一般還有幾丁質的真核微生物。一般包括真菌,粘菌和假菌(卵菌等)3類。 |